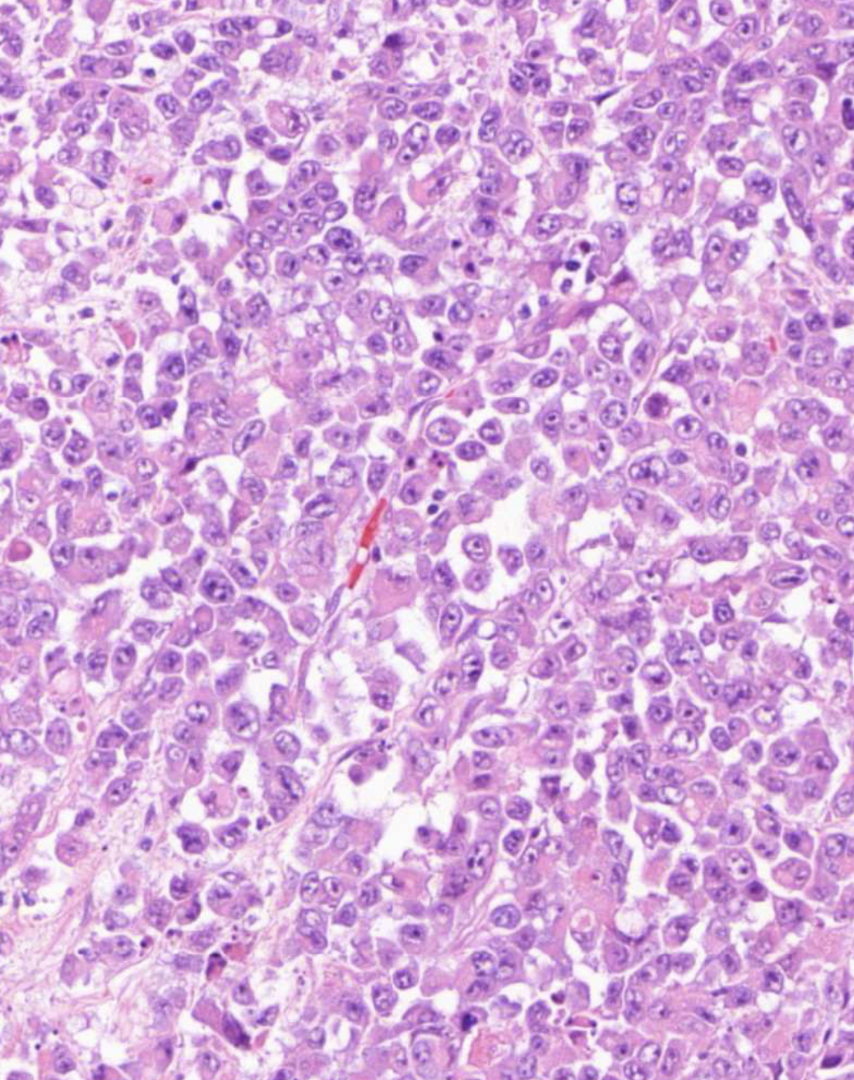
knowt flashcard image

Pathology histology - Colon cancer
1/33
Earn XP
Description and Tags
Pathology histology
Name | Mastery | Learn | Test | Matching | Spaced | Call with Kai |
|---|
No analytics yet
Send a link to your students to track their progress
34 Terms

Normal colon

Normal colon - Circular muscle (inner layer)


Normal colon - Crypt
Crypt = Tubular gland located in the mucosa
Lined by goblet cells

Normal colon - Enterocyte

Normal colon - Enteroendocrine cell

Normal colon - Goblet cell

Normal colon - Lamina propria
Contains mainly immune cells


Normal colon - Lympho-glandular complex
Normal numbers of immune cells (mainly lymphocytes)

Normal colon - Mucosa

Normal colon - Submucosa

Normal colon - Muscularis externa

Normal colon - Muscularis mucosae

Normal colon - Serosa
Adipose tissue

Well differentiated colon adenocarcinoma


Gland-like structures at wrong location in well differentiated colon adenocarcinoma

Well differentiated colon adenocarcinoma - Mucosa area

Well differentiated colon adenocarcinoma - Muscularis externa layers

Well differentiated colon adenocarcinoma - Submucosa area


Well differentiated colon adenocarcinoma - Tumour cells
Nuclei on different levels (not in a row at the bottom of the cells as in normal crypts)

Well differentiated colon adenocarcinoma
Different sized, closely bound gland-like tubule/crypts
Cell debris in the lumen of the glands (necrotic cell remains mixed with inflammatory cells ) - can be a sign of relative lability of the cancer cells and/or be caused by ischaemia
No lamina propria between, located very close to each other - Pushed together, not growing in a normal way

Well differentiated colon adenocarcinoma - Cylindrical epithelial cells of cancer glands
Irregular structure
Sometimes form several layers (pseudo stratified) due to compression
Densely packed
Polymorphic
Varied sizes and configurations
Relatively large nuclei and hyperchromatic
The mucin level in the cytoplasm is severely reduced compared to normal
Mitosis is frequent
Prominent nuceolus
Not all nuclei is not at the bottom of the cell as they are normally - Nuclei are not arranged in a straight line

Superficial growing colon adenocarcinoma
On the “right” side of the muscularis mucosa

Invasive colon adenocarcinoma
On the “wrong” side of muscularis mucosa

Well differentiated colon adenocarcinoma - Invasive cancer glandular structures in submucosa
Not a good prognosis

Well differentiated colon adenocarcinoma - Large groups of invasive cancer cells on wrong side of muscularis externa
Large clusters of cancer structures
Forming into glandular structures
Large nuclei
Varied location of nuclei
Tumour has infiltrated all the walls of the intestine, reached the fat tissue and also the muscle tissue here to some extend
Why is all of these images diagnosed as well differentiated colon adenocarcinoma and not poorly differentiated?
Even though there are cancer cells present that are morphologically different from normal, they are still forming some kind of tubular structure (not the normal shape, but still there) → Well differentiated
Morphology gives us an indication of the likely behaviour of this cancer
Good sign, but unfortunately it has spread through the intestinal wall


Poorly differentiated colon adenocarcinoma areas

Lymph node - No signs of metastasis
Looks normal
No cancer cells can be identified → Positive sign
Capsule, normal follicular structure

Poorly differentiated colon adenocarcinoma - Mucosa

Poorly differentiated colon adenocarcinoma - Muscularis externa

Poorly differentiated colon adenocarcinoma - Necrosis in tumour

Poorly differentiated colon adenocarcinoma - Serosa
The serosa is facing the peritoneal cavity
Adipose tissue on the other side of the muscularis externa

Poorly differentiated colon adenocarcinoma - Serial surface
A bit damaged during surgery
No apparent visible mesothelium
Poorly differentiated colon adenocarcinoma - Cancer cells
Not arranged in any particular pattern (no crypt or glandular-like structures) → poorly differentiated (little to no resemblance of normal structure) → worse prognosis
Mitosis can be seen